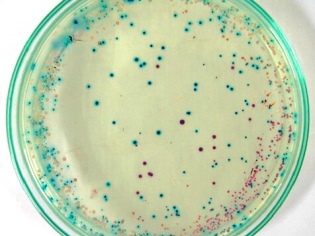

Лечение белого налета на гландах и миндалинах
Когда на гландах появляется налет, сопровождающийся как болью, так и без нее, важно помнить, что это всего лишь признак. Нельзя избавиться от него только с помощью симптоматической терапии, необходимо провести полноценное лечение основного заболевания, включающее в себя:
- Лечение бактериальных инфекций, таких как дифтерия, бактериальная ангина и стоматит.
- Терапия вирусных заболеваний, таких как ОРЗ, вирусные ангины и стоматиты.
- Борьба с грибковыми инфекциями, такими как фарингомикозы или молочница.
- Использование дезинфицирующих растворов для удаления пленки с миндалин и ротовой полости.
- Удаление гнойной пленки с миндалин при помощи специального шприца с раствором (эту процедуру проводят только в больнице).
- Средства для снижения температуры при лихорадке.
- Применение обезболивающих препаратов при сильных болях в миндалинах.
- Применение иммуномодуляторов.
- Соблюдение бережного режима для горла: избегание острой пищи, громких и продолжительных разговоров.
- Питье в больших количествах.
- Применение поливитаминов при ослабленном иммунитете.
Запрещается самостоятельно выбирать лекарства для удаления гноя из миндалин. Без профессиональной диагностики и консультации специалиста невозможно определить тип возбудителя и, следовательно, правильное лечение.
Использование антибиотиков для лечения вирусных инфекций не только неэффективно, но также может быть опасным из-за возможного снижения иммунитета и удлинения периода болезни с различными осложнениями. Аналогичные последствия могут возникнуть при применении противовирусной терапии для микозов или бактериальных инфекций.
Промывания и полоскания
Очистка миндалин проводится профессионалами только в поликлинических условиях
Необходимо проявить особую осторожность при выполнении этой процедуры, чтобы избежать травмирования миндалин. Она может быть неприятной и вызывать некоторое болевое ощущение, поэтому особенно важно бережно удалять белый налет с горла у ребенка.
Существуют и ограничения для этой процедуры: ее не следует проводить во время беременности, онкологических заболеваниях, тяжелой гипертонии, открытом туберкулезе, нарушениях вегетативной части нервной системы. Однако правильное промывание эффективно очищает белое горло при различных причинах образования налета.
Процедура промывания миндалин в медицинском учреждении
Использование полосканий может быть разнообразным: от доступных домашних рецептов (раствор соды и соли, отвар ромашки, фурацилиновый раствор) до более дорогих аптечных средств. Основное требование – регулярность проведения процедур. Если полоскания горла проводить редко, то желаемого эффекта не будет достигнуто, поскольку гной накапливается вновь всего за несколько часов.
Чтобы избавиться от микробов, остатков пищи и иммунных клеток, рекомендуется проводить ополаскивания регулярно — раз в час или по рекомендации врача. Это поможет предотвратить образование благоприятной среды для жизни микроорганизмов, что в свою очередь сделает миндалины менее красными и уменьшит их болезненность.
Более высокая эффективность этих методов достигается при регулярной проведении гигиенических процедур для ухода за полостью рта. На поверхности зубов образуется налет, который также содержит бактерии и может стать источником их распространения на миндалины, гортань и даже легкие.
Причины появления белых пятен на миндалинах у ребенка
Лимфоузлы, покрытые белесым налетом, не могут эффективно выполнять свою защитную функцию. Это может привести к развитию серьезных заболеваний. Для полного выздоровления необходимо устранить причину появления белого налета.
Если есть температура
Если у ребенка, кроме белых точек на миндалинах, есть повышенная температура тела, то следует обратиться к педиатру. Эти признаки могут указывать на серьезное заболевание. Без соответствующего лечения состояние будет только ухудшаться, что может привести к развитию осложнений и переходу патологии в хроническую форму.
Если у малыша наблюдается повышение температуры тела, то появление белых пятен на миндалинах может быть вызвано:
- При острой форме тонзиллита, известной как ангина, помимо появления белых отложений, возможно образование гнойников. Это состояние сопровождается краснением и болями в горле, а также повышением температуры до 39 градусов.
- Хронический тонзиллит развивается в результате продолжительного воспаления миндалин после перенесенных вирусных инфекций, сопровождавшихся воспалением зева.
- При гриппе, ОРВИ или фарингите первые признаки этих заболеваний могут проявиться у детей в виде белых точек на миндалинах.
- Дифтерия характеризуется появлением белых отложений на миндалинах, сопровождающихся температурой до 40 градусов. В запущенных случаях это состояние может привести к сердечно-сосудистым проблемам или нарушениям в работе нервной системы. Дифтерия является инфекционным заразным заболеванием, поэтому ребенка с этим диагнозом необходимо госпитализировать и изолировать от контакта с другими людьми.
Также у родителей может возникнуть замечание о появлении белых точек во рту у ребенка при наличии скарлатины.
Если нет температуры
Иногда возникают белые отложения на миндалинах без повышения температуры. Это происходит, когда пищевые частицы попадают в пористые миндалины. Тщательное полоскание рта помогает быстро решить эту проблему. Однако иногда налет может быть признаком серьезного заболевания.
Факторы, вызывающие образование белых точек на гландах при нормальной температуре тела:
- Стоматит. Помимо образования налета у ребенка, можно заметить увеличение лимфоузлов подчелюстной области, увеличение выделения слюны. На миндалинах появляются эрозии и язвы. Травмы, аллергии, переохлаждение и пониженный иммунитет могут стать причинами стоматита. Эта болезнь может осложняться гангреной, потерей голоса и выпадением зубов.
- Кандидоз. Грибковое поражение может возникнуть в результате лечения антибактериальными препаратами. Антибиотики не только подавляют патогенные микроорганизмы, но и разрушают полезную микрофлору, что способствует активизации размножения дрожжеподобного грибка. Кандидоз проявляется образованием белого сырообразного налета на миндалинах и язвах.
- Лейкоплакия. Характеризуется образованием роговых утолщений на слизистой оболочке ротовой полости. Этот процесс может сопровождаться появлением белых пятен на миндалинах и наличием гнойников.
Не рекомендуется пытаться самостоятельно определить и устранить причину образования точек на миндалинах у ребенка. Для предотвращения ухудшения ситуации наилучшим решением будет обратиться к педиатру.
Ангина представляет опасность в том, что она способна вызывать серьезные осложнения для желчного пузыря, сердца, сосудов и почек.
Способы терапии
Антибиотики
При наличии ангины без повышения температуры или при хроническом тонзиллите необходимо принимать антибиотики, которые помогут побороть болезнетворные бактерии. Антибиотики должны эффективно уничтожать стрептококки и обязательно назначаются только квалифицированным врачом.
Промывание
Этот метод считается действенным и простым (хотя немного неприятным) способом удаления зубного налета. Он проводится в клинике и представляет собой механическое удаление налета с использованием специального раствора.
Выполняется процедура с применением шприца с наконечником. Особенно дети не любят эту манипуляцию, поскольку иногда она может быть болезненной. Важно отметить, что промывание лучше всего использовать как часть комплексного лечения, а не в качестве единственного метода.
Полоскания
Один из необходимых методов комплексной терапии воспаления миндалин. Этот метод отлично удаляет гной и налет из полости рта, способствуя тем самым выздоровлению.
Антимикробные ингредиенты, содержащиеся в жидкостях для полоскания, способствуют уничтожению вредоносных микроорганизмов. В качестве составляющих для приготовления жидкостей можно использовать следующие:
- йод;
- растения для лечения;
- антисептическое средство.
- Сода. Промывание горла содой хорошо тем, что этот метод отлично удаляет гной с поверхности миндалин.
Признаки и методы лечения воспаления носоглотки подробно описаны .
Чтобы ускорить выздоровление, рекомендуется проводить полоскания чаще всего — не менее 10 раз в день. При соблюдении этого условия, ощутимое улучшение состояния не заставит себя долго ждать. Кроме упомянутых методов, в качестве дополнительной терапии можно использовать специальные спреи для орошения горла.
Если причиной образования налета является кандидоз, то полоскание содой в сочетании с приемом антигрибковых препаратов может оказать помощь. При выявлении лейкоплакии особенно важно проведение грамотного и своевременного лечения из-за возможного риска развития рака. Однако подбирать подходящую терапию следует только врачу: в данном случае самолечение особенно опасно.
Дополнительные способы терапии
Альтернативные способы лечения также могут привести к хорошим результатам, если использовать их в дополнение к основному лечению.
Если на миндалинах появился белый налет из-за хронического тонзиллита, рекомендуется прибегнуть к применению настойки прополиса. Она обладает антисептическим эффектом и способна устранить множество различных бактерий.
Используйте ватную палочку для нанесения средства один или два раза в течение дня.
Если поражение произошло только с одной стороны, то необходимо удалить серую пленку именно с пораженной миндалины, не затрагивая здоровую область.
Если вы заметили белый налет на задней стенке горла, то можно прибегнуть к использованию отвара шалфея для полоскания. Этот природный растительный препарат обладает выраженным противовоспалительным эффектом, который может помочь в борьбе с этим неприятным симптомом.
Для приготовления отвара потребуется 1 столовая ложка сырья, которую следует залить 200 мл кипятка, поварить в течение 5-10 минут и оставить настаиваться примерно полчаса. После этого отвар необходимо процедить и использовать для полоскания трижды в течение дня.
Заваренный настой из цветков ромашки также эффективно борется с воспалительным процессом в миндалинах. Для этой цели следует заварить 2 чайные ложки сырья в 300 мл кипятка.
После этого нужно оставить настояться около 40 минут. После этого следует профильтровать смесь. Рекомендуется применять 3 раза в день для полоскания горла.
Необходимо активно укреплять свой иммунитет. Для этого рекомендуется принимать специальные лекарственные средства, содержащие интерферон
Также возможно использовать естественные иммуномодуляторы. Сюда относятся мед, прополис, перга и другие.
Если грибковая инфекция сосредоточилась на задней стенке горла, то следует использовать исключительно прополис.
Применение меда может лишь усилить проявление симптомов. В качестве дополнительного средства лечения можно воспользоваться отваром шиповника, который эффективно укрепляет защитные силы организма.
Для уменьшения силы воспаления и удаления налета рекомендуется применять отвар календулы. 1 чайную ложку следует развести в 150 мл теплой воды и использовать для полоскания горла 3 раза в день.
После проведения процедуры рекомендуется воздержаться от приема пищи в течение примерно часа.
Как лечить налет на гландах
Для быстрого восстановления здоровья и предотвращения осложнений, а также предотвращения перехода заболевания в хроническую форму, важно немедленно обратить внимание на появление белого на миндалинах
В зависимости от того, какой бактерия вызвала воспаление, врач может рекомендовать применение:
1
Препараты противовирусной терапии представляют собой первичные средства, которые можно использовать при появлении начальных симптомов простуды.
Иммуномодуляторы способствуют укреплению защитных функций организма, что приводит к более быстрому уничтожению возбудителей и предотвращению развития серьезных нарушений состояния.
Среди наиболее эффективных противовирусных препаратов можно выделить: Препараты на основе интерферона, Назоферон, Оцилококцинум, Изопринозин, Афлубин, Анаферон, Вибуркол, Протефлазид и другие.
2
Применение антисептических растворов. Если начать полоскать горло антисептиками вовремя, можно предотвратить развитие инфекции на ранних этапах.
Однако они также применяются на более поздних стадиях развития заболеваний, поскольку они помогают устранить гнойное отложение.
Обычно для этого используются: препараты Ротокан, раствор Фурацилина, Стрептоцида, Хлорофиллипта, Мирамистина. Если их нет под рукой, можно просто промыть рот слабым раствором пищевой соды.
3
Применение антибиотиков является основным способом борьбы с бактериальной флорой, которая является основной причиной образования белого налета на гландах.
Их цель — уничтожить клетки микроорганизмов, что приводит к их уничтожению. Сначала пытаются решить проблему с помощью местных средств, таких как Полидексы или Изофры.
В случае респираторных инфекций, обычно применяют антибиотики из группы пенициллинов (например, Аугментин, Ампициллин), макролиды или цефалоспорины.
4
Антимикотики. Препараты против грибков назначаются только для лечения кандидоза полости рта. Сначала рекомендуется использовать специальные местные средства для обработки пораженных участков, такие как препарат Кандидом.
Однако, если не наблюдается необходимого результата, их заменяют лекарствами: Флуконазол, Итрунгал, Низорал, Орунгал, Микосист, Дифлюкан и другими.
5
Препараты в виде таблеток, пастилок и спреев играют важную роль в снятии болевых ощущений и оказывают местное противовоспалительное воздействие.
На сегодняшнем рынке фармацевтических препаратов можно найти огромное количество различных продуктов: Стрепсилс, Лисобакт, Фарингосепт, Септолете, Трахисан, Тос-Май, Исла-Моос, Септефрил, Лизак и многие другие.
6
Препараты, которые обычно используются вместе с антибиотиками, — это антигистаминные препараты. Среди них: Лоратадин, Эдем, Эриус, Диазолин, Супрастин, Фенистил.
Часто врачи также рекомендуют профессиональное удаление слизи в специально оборудованном кабинете отоларинголога.
Процедура предполагает использование специального раствора, который механически удаляет загрязнения из полости рта при помощи шприца с особым наконечником. Хотя процесс может быть неприятным, он является эффективным способом очистки.
Причины
Чаще всего детей заражают вирусные инфекции, которые проявляются самыми разнообразными симптомами, включая появление белого налета на миндалинах. Белые пятна, которые постепенно увеличиваются в размерах и становятся похожими на пятна, могут возникнуть при определенных формах ангины. В этом случае наблюдается значительное увеличение размеров миндалины. Белые пузырьки часто являются признаком стоматита, они быстро распространяются и затрагивают другие участки ротоглотки — язык, внутреннюю сторону щек, десны, глоточное кольцо.
Отсутствие высокой температуры практически всегда связано с возникновением грибкового налета. Поражение грибками считается крайне опасным, поскольку оно способно быстро распространяться и иногда затрагивает внутренние органы.
В следующем списке перечислены лишь некоторые из возможных причин появления белого налета на миндалинах:
- Стоматит. Происхождение этого заболевания в медицинской практике пока не до конца ясно, и до сих пор нет однозначного ответа на вопрос, почему лимфоциты внезапно начинают атаковать мирные и родственные слизистые оболочки полости рта. Существует предположение, что такую реакцию могут вызывать вирусы или микробы, но довольно часто лабораторные анализы не подтверждают наличие того или другого. Белый или слегка желтоватый налет на гландах (миндалинах) обычно обнаруживается на довольно запущенной стадии стоматита. Повышенной температуры при стоматите обычно не наблюдается, и если она и возникает, то держится на субфебрильных значениях — 37,0-37,50.
- Образование кист на миндалинах является доброкачественным и обычно связано с нарушением функций лимфоидной ткани. Кисты могут возникать как отдельно, так и группами. Они легко заметны и могут вызвать у ребенка першение, ощущение постороннего предмета в горле при глотании, изменение голоса и затрудненное носовое дыхание. Белый налет обычно образуется вокруг кисты и не распространяется дальше. При этом у ребенка может отсутствовать повышение температуры.
- Фарингомикоз — это заболевание, вызванное грибками, которые поражают горло. В начале возможно принять его за обычный фарингит, но это заблуждение довольно опасно. При фарингомикозе колонии грибков быстро размножаются и, если не начать специфическое противогрибковое лечение, они могут поразить внутренние органы. Белый налет появляется как в горле, так и на миндалинах, и имеет очаговый характер. Если причиной болезни стали грибки типа «кандида», то налет будет молочно-белым, а если плесневые грибки, то немного желтоватым. Процесс может протекать без повышения температуры.
- Ангина — у всех видов этого заболевания характерны изменения в миндалинах. Они становятся отечными, воспаленными, и при некоторых формах ангины на ярко-красной, контрастной миндалине появляются белые бляшки, гнойнички. При бактериальной ангине Симоновского – Паута – Венсана налет на миндалине выглядит, как натянутая тонкая пленка бело-грязного серозного цвета. Практически всегда заболевание характеризуется острым течением, высокой температурой и сильной болью в горле. Любые формы ангины при неправильном лечении могут привести к появлению гнойников, прыщиков, белых пятен и пробок на миндалинах.
- Дифтерия. Во время этого серьезного инфекционного заболевания пораженные миндалины и горло сильно отекают, что может привести к нарушению дыхания у детей. На пораженных участках образуется белый налет в виде пленки, которую удаляя, можно обнаружить кровоточащие ранки. Недавно дифтерия считалась смертельной болезнью, однако сейчас все дети определенных возрастных групп обязательно прививаются от дифтерии (АКДС). Поэтому вероятность заразиться этим заболеванием не так велика, как казалось ранее. Тем не менее, полностью исключать опасность все равно не стоит.
- Аденоиды. Этот диагноз чаще всего устанавливают у детей в возрасте от 2 до 7 лет. У малышей возникают проблемы с носовым дыханием, иногда оно полностью нарушается. Это связано с увеличением глоточной миндалины. Обнаружить налет и увеличение глоточной миндалины может только детский отоларинголог, поскольку ее расположение таково, что без специального зеркала невозможно рассмотреть задний проход носоглотки. Налет при аденоидном заболевании появляется в период обострения, которое часто происходит на фоне простуды или вирусной инфекции.
Другие патологические состояния глотки
Изображение демонстрирует поражение полости рта грибковой инфекцией
Появление изменений в области горла может быть связано с грибковым поражением полости рта. Это проявляется у людей с ослабленным иммунитетом (например, у ВИЧ-инфицированных, при приеме цитостатиков и других препаратов) или в результате длительной антибиотикотерапии. В полости рта обитают грибы рода Candida и другие, которые образуют белое налет практически на всей поверхности ротоглотки.
Реже путают с налетом гнойные пробки, которые встречаются при хроническом тонзиллите. Особенностью этих пробок является отсутствие симптомов острого воспалительного процесса при наличии белых творожистых масс на миндалинах. Врач может легко удалить их с помощью специальных процедур (вакуум-аспирация, промывание миндалин).
Любые изменения и появление отложений в области горла свидетельствуют о наличии острой или хронической болезни в организме. Чтобы уточнить диагноз и подобрать соответствующее лечение, рекомендуется обратиться к оториноларингологу и пройти необходимые обследования.
Лечение
Давайте рассмотрим различные методы лечения в зависимости от конкретного заболевания:
- При разработке методов лечения заболеваний, вызванных бактериальной инфекцией, применяются антибиотики. Часто прописываются препараты Аугментин, Ампициллин. Если желаемый результат от антибиотиков данной группы не достигается после 3 дней приема, то рекомендуется пересмотреть выбор препаратов. Прерывать курс лечения не рекомендуется, даже если белый налет начинает исчезать, поскольку минимальная продолжительность курса составляет 5 дней. В случаях тяжелого течения заболевания необходимо применение системных препаратов.
- Лечение заболеваний, вызванных вирусной инфекцией, включает прием противовирусных препаратов (Афлубин, Назоферон, Интерферон, Вибуркол и другие). Они способствуют активации защитных функций организма, повышая его сопротивляемость к вирусам.
- Грибковые инфекции требуют комплексного подхода, включающего как внутренние препараты, так и средства для местного применения. Продолжительность курса лечения в среднем составляет 14 дней. Для достижения максимального эффекта его рекомендуется повторить через определенный промежуток времени. Среди наиболее популярных средств можно выделить: Кандидом, Орунгал, Микосист, Низорал и другие.
- Для облегчения болевых ощущений рекомендуется использовать: Стрепсилс, Септефрил, Трихасан, Тос-Май, Исла-Моос и другие.
В дополнение к лекарствам, которые назначает врач, проводят полоскание горла и обрабатывают различными растворами.
- размолотую таблетку Фурацилина (или Стрептоцида) следует растворить в теплой воде и использовать для полоскания каждые 30-60 минут;
- применить Винилин для обработки миндалин ватной палочкой;
- промыть гортань антисептическим раствором Мирамистина;
- использовать отвар ромашки и тысячелистника для полоскания;
- произвести полоскание с помощью содового раствора.
Для выявления проблемы на ранней стадии иногда приходится прибегать к хирургическому вмешательству. Это экстремальная мера, используемая в ситуациях, когда лечение затягивается. Поэтому откладывать визит в клинику на более поздний срок не рекомендуется.
Кстати, чтобы избавиться от налёта на миндалинах или слизистой, иногда необходима помощь специалиста. Процедура несложная, но может вызывать дискомфорт. Она включает в себя промывание полости рта специальным раствором, который вводится с помощью шприца с особым наконечником.
Важно, чтобы взрослые уделяли больше внимания своим детям, особенно в период межсезонья, когда влажность повышается, а температура падает. Регулярное обследование гортани у детей поможет выявить возможные проблемы, такие как покраснение, налет или наличие слизи.
проявления) на ранней стадии и использовать наиболее эффективное лечение без применения антибиотиков и хирургических процедур.
Постоянное обследование гортани у детей поможет выявить проблему (например, покраснение, налет, слизь и другие признаки) на ранней стадии и применить наиболее эффективное лечение без применения антибиотиков и хирургических вмешательств.
При необходимости применения системных препаратов подбирается индивидуальный антибиотик для каждого ребёнка с учётом типа микробов, поразивших организм. В этом случае часто используются препараты, такие как Флемоксин, Амоксициллин и другие.
Для устранения неприятных симптомов рекомендуется использовать препараты: Амизон, Фарингосепт, Лизобакт. Также можно проводить полоскания свекольным соком, лимонным соком, содовым раствором или раствором таблетки Фурацилин в теплой воде. Такие процедуры помогут не только избавиться от микробов, но и от белого налета.
Информация! Если малыш получает грудное питание или употребляет грудное молоко, то наличие белого налёта считается нормальным. Чтобы убедиться, что с ребёнком всё в порядке, нужно обратить внимание на его поведение. Здоровые дети ведут себя нормально: играют, веселятся, придерживаются обычного режима дня.
Лечение тонзиллита у детей
Перед тем, как приступить к назначению лечения, врачу необходимо удостовериться, какая разновидность заболевания проявляется у маленького пациента.
Необходимо начать лечение хронического тонзиллита сразу после установления диагноза педиатром. Поскольку причиной заболевания является бактериальная инфекция, симптоматическое лечение не будет эффективным. Доктор Комаровский настоятельно предупреждает, что применение сосательных таблеток или леденцов в лечении ангины категорически запрещено. Даже в инструкции указано, что они имеют вспомогательный характер. Необходимо бороться с вредоносными микроорганизмами.
При заболевании ангиной, Комаровский настаивает на необходимости применения антибактериальных препаратов. Вместе с лечением причины заболевания, рекомендуется проводить симптоматическую терапию. Это может включать в себя применение леденцов от боли в горле или спрея. Они помогают уменьшить дискомфорт, вызванный тонзиллитом.
Индивидуальная дозировка и продолжительность курса лечения устанавливаются педиатром для каждого ребенка в зависимости от типа и тяжести заболевания.
Если острый тонзиллит сопровождается повышенной температурой, врач рекомендует принимать жаропонижающие препараты. Чаще всего у детей используются лекарства, основной компонент которых – Парацетамол или Ибупрофен. Снижать температуру рекомендуется, если она превышает тридцать восемь градусов. По мнению доктора Комаровского, детский организм должен самостоятельно противостоять бактериальной инфекции. Врачи назначают препараты, которые помогают организму преодолеть заболевание.
При своевременном начале терапии острый тонзиллит быстро снимется. Неправильное лечение или его отсутствие может привести к затяжному процессу хронической формы заболевания, постоянно подчеркивает Евгений Комаровский. Лечение хронического тонзиллита представляет значительные трудности.
Множество людей прислушиваются к мнению Евгения Комаровского. Всем известно, что известный педиатр придерживается взгляда, что большинство заболеваний следует лечить более традиционными методами. Однако, в случае с ангиной, он придерживается другого мнения. Что касается хронической формы тонзиллита, Комаровский рекомендует не только медикаментозное лечение, но и акцентирует внимание на режиме и процедурах для укрепления иммунитета. Конечно, при обострении хронического тонзиллита необходимо избегать переохлаждения и длительного нахождения на улице. Эти процедуры он предлагает в качестве профилактики.
Если хронический тонзиллит не поддается лечению, врачи могут порекомендовать удаление миндалин. Доктор Комаровский советует не откладывать лечение, чтобы избежать необходимости проведения операции. Миндалины выполняют защитную функцию. После удаления организму труднее справляться с вредными патогенами самостоятельно.
Методы лечения воспаления миндалин у детей.
Профилактика и рекомендации
При обнаружении белых пятен на миндалинах важно незамедлительно обратиться к специалисту. Несмотря на то, что это состояние может показаться незначительным, без своевременного лечения оно может привести к развитию опасных осложнений.
Итак, со временем хронический тонзиллит может привести к следующим последствиям:
- заболеваний сердечно-сосудистой системы;
- ревматических заболеваний;
- патологий суставов;
- нарушений функций печени и других внутренних органов.
Для предотвращения подобных последствий, рекомендуется правильно лечить ангину и другие острые респираторные заболевания, проходя полный курс лекарств. Также важно отказаться от курения и как минимум раз в год проходить профилактический осмотр у оториноларинголога.
Помните
Во время процесса выздоровления необходимо избегать употребления острой, холодной и жесткой пищи. Это может нанести вред слизистой оболочке и спровоцировать появление язв.
Рекомендуется воздержаться от применения горячих компрессов, поскольку тепло способствует размножению бактерий. Вместо этого целесообразно увеличить количество потребляемой жидкости: воды, теплого чая, натуральных соков.
Эффективным способом предотвращения инфекционно-воспалительных заболеваний будет:
- укрепление организма;
- соответствующее питание;
- отказ от вредных привычек, особенно от курения;
- избегание стрессов и излишней усталости.
Частые вопросы
Каковы причины появления белого налета на миндалинах?
Белый налет на миндалинах обычно является результатом накопления бактерий, остатков пищи и отмерших клеток на их поверхности.
Какие методы помогают избавиться от белого налета на миндалинах?
Для удаления белого налета на миндалинах рекомендуется регулярно промывать рот антисептическими растворами, использовать специальные оральные промывания и поддерживать хорошую устную гигиену.
Полезные советы
СОВЕТ №1
Белый налет на миндалинах может быть признаком микробного или грибкового поражения. Рекомендуется обратиться к врачу для проведения диагностики и назначения соответствующего лечения.
СОВЕТ №2
Для профилактики белого налета на миндалинах регулярно промывайте ротовую полость с помощью антисептических растворов или отваров лекарственных трав.